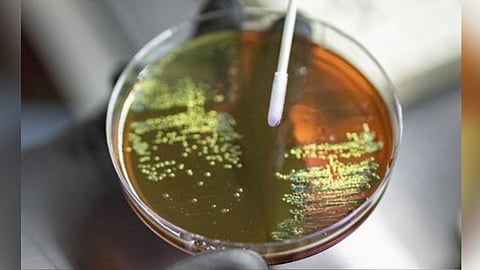
Representative Image

NEW DELHI: Maternal use of antibiotics during pregnancy may raise the risk of babies developing Group B Streptococcus (GBS) disease -- a common bacterial disease, according to a study.
While the bacteria usually live harmlessly in the gut or genital tract, they can cause serious infections, especially in newborns, older adults, and immunocompromised individuals, leading to sepsis, meningitis, and pneumonia.
The study led by an international team from Karolinska Institutet in Sweden, University of Antwerp in Belgium, showed that prenatal antibiotic exposure was associated with an increased risk of neonatal GBS disease, within four weeks of delivery. Early third-trimester exposure showed the strongest association.
“Prenatal antibiotic exposure can raise GBS risk within four weeks postpartum, especially in neonates not covered by risk-based intrapartum prophylaxis, with the early third trimester being a critical window of susceptibility,” said the researchers in the paper in the Journal of Infection.
The team conducted a population-based cohort study including all singleton live births in Sweden from 2006 to 2016, using national registers.
Among 1,095,644 liveborn singletons, 24.5 per cent were exposed to antibiotics.
GBS incidence was found to be higher among exposed neonates than unexposed (0.86 vs. 0.66 per 1,000 live births), particularly among neonates without GBS risk factors.
According to the researchers, the study is the first to examine prenatal antibiotic exposure in relation to the risk of neonatal GBS disease. However, it aligned with previous Nordic studies, which reported a 16-34 per cent increased risk of infections during early childhood (ages 1-5 years) following prenatal antibiotic exposure.
The study found that GBS-active antibiotics given close to delivery (within four weeks) offered no protection.
The association of prenatal exposure to any antibiotics with neonatal GBS disease appeared to depend on the presence of clinical GBS risk factors, with a positive association observed only among pregnancies without such risk factors.
This suggests that neonates without established GBS risk factors may benefit more from limiting prenatal antibiotic exposure, the team said.
Calling for more research, the team also underscored the need for increased vigilance in monitoring neonates who fall outside existing GBS prevention guidelines, particularly those exposed to antibiotics in utero during the early third trimester.